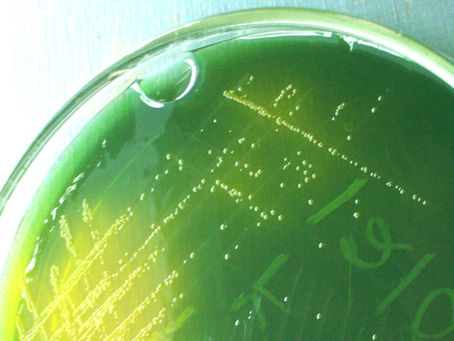
Destroy all Vibrio: How PNSB Safeguard Against Disease

top of page
Search


Use of Purple NonSulfur Bacteria (PNSB) as Fish Probiotics
The potential of PNSB as probiotics in aquaculture is still being explored; future developments could further enhance their application.

Hydrospace LLC
Sep 2, 20248 min read


Marichromatium in Aquaculture: What Does the Science Tell Us So Far?
The intensification of aquaculture has necessitated the exploration of innovative solutions to improve sustainability and productivity....

Hydrospace LLC
May 31, 20246 min read


Of Microbes and Mangroves: PNS Bacteria and Rhizophora mangle
Mangroves are one of those keystone species which have the potential to redefine the greater aquarium hobby. Mangroves are organisms...

Taras Pleskun
Dec 17, 202311 min read


A Brief History of Purple Non-Sulfur Bacteria in Aquaculture and Aquarium Keeping
As we stand at the cusp of a new era, PNS bacteria continue to evolve as indispensable assets in aquaculture and aquarium management.

Hydrospace LLC
Dec 16, 20235 min read


PNS Bacteria Shown to Promote Growth of Other Probiotics
PNS bacteria can do a lot to improve aquarium animals’ diets all the way down the food chain–from protists to copepods to fish and corals.

Hydrospace LLC
Jul 8, 20232 min read


The Natural Probiotic? PNSB Shown to be Part of Indigenous Fish Gut Microbiota
The word ‘probiotic’ can mean different things in different discussions. Most often, it refers to microbes that benefit a host organism...

Hydrospace LLC
May 12, 20234 min read


PNS YelloSno™, Photofermentation and The Coral Reef Environment
For millennia, humans have utilized fermentation to produce an enormous variety of beneficial products. Early Europens fermented hops and...

Taras Pleskun
Jan 9, 20237 min read


I Grew My Own Phototrophic Bacteria with PNS HomeGro™ Kit and So Can You! (Part 1)
The ability to ‘scale up’ larger cultures from an initial purchase is one of the highest criteria I have for evaluating the worth of any...

Taras Pleskun
Dec 24, 20227 min read


Microbiomes of Coral Mucus and Seawater Relate to Specific Coral Metabolic Functions
In a paper recently published in Environmental Microbiology, researchers examined the microbiome (for both taxonomy and function) in the...

Hydrospace LLC
Oct 30, 20222 min read

Destroy all Vibrio: How PNSB Safeguard Against Disease
Not all microbes are created equal. Each phylum, class, family, genus, species, strain and cell is imparted with a particular genetic...

Taras Pleskun
Jul 1, 202212 min read


Duel of the Microbes: Rhodospirillum rubrum vs Rhodopseudomonas palustris
Purple non-sulfur bacteria represent the vanguard of our growing library of powerful probiotics. How do they differ from each other?

Taras Pleskun
May 15, 20227 min read


DMSP and Coral-Associated Bacteria
DMSP accumulation can negatively impact coral health (e.g. RTN). Meet the bacteria that reduce this risk.

Hydrospace LLC
Jan 8, 20223 min read


Nutrients from the Sky: Diazotrophy, Plants and PNS Bacteria
Diazotrophy is the ability to biologically fix atmospheric nitrogen gas (N2) into ammonia (NH3). This magical process allows otherwise...

Taras Pleskun
Nov 17, 202111 min read


PNS Bacteria and the American Shrimp Farmer
America Loves Shrimp. This remains a persistent truth as over 500,000 metric tons of shrimp are consumed in the United States each year....

Taras Pleskun
Oct 5, 20219 min read


Powerful Pigments: Carotenoids and PNS Bacteria
Pigments are organic molecules of unbelievable power. Bacteria, archaea, algae, plants and other photoautotrophs create pigments to...

Taras Pleskun
Sep 16, 20219 min read


Using PNS Substrate Sauce
We all agree that it is critically important to “cycle” an aquarium before stocking sensitive animals such as fish, clams, etc. But we...

Hydrospace LLC
Aug 5, 20219 min read


From Waste to Nutrition: Fatty Acid Profile of PNS Bacteria
Purple non-sulfur bacteria (PNSB) are potent and multifaceted biofiltration agents. Due to their Swiss army knife metabolism, PNSB such...

Taras Pleskun
Jul 8, 20219 min read


PNS Bacteria: Denitrification Powerhouses
Every aquarist possesses a baseline knowledge of nitrification. This is the oxidization of ammonia into nitrate by certain aerobic...

Taras Pleskun
May 30, 20218 min read


How to Dose the PNS Products
It’s totally understandable if you have a few questions about dosing the PNS (purple non-sulfur) bacteria-based products PNS ProBio, PNS...

Hydrospace LLC
May 15, 20213 min read


How PNS Bacteria Promote a Healthier Aquarium
In the aquarium hobby, there are Good Tanks and there are Bad Tanks. Good Tanks are stable, do not experience abrupt fluxes in water...

Taras Pleskun
Apr 10, 20217 min read

bottom of page